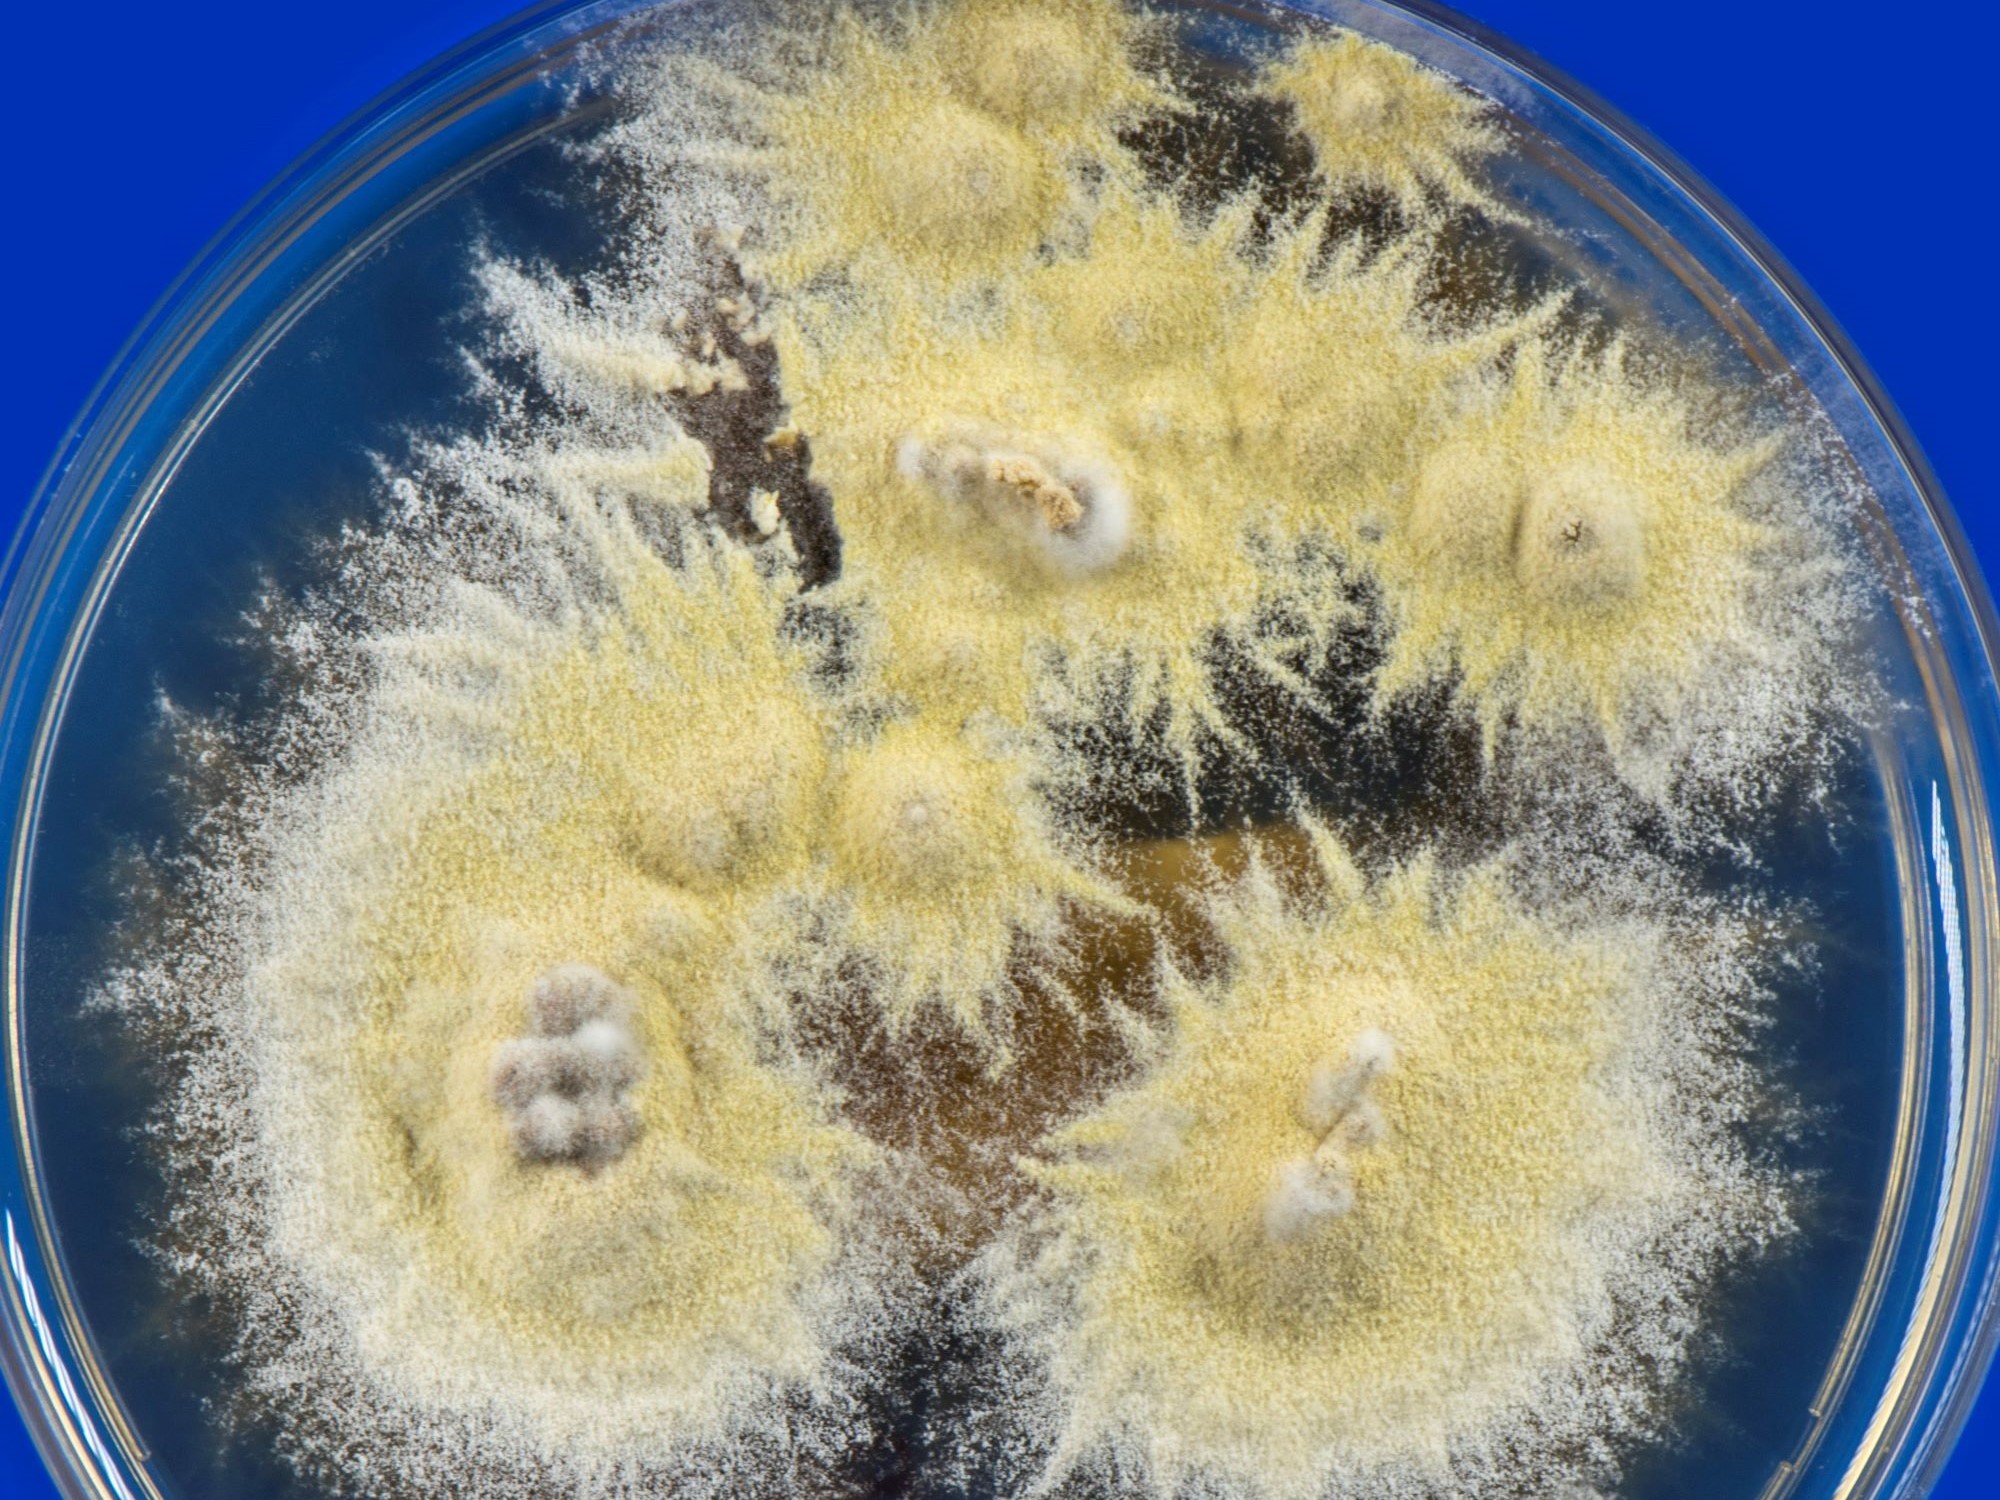
LABOPART Trichophyton mentagrophytes

Troglohyphantes es un género de arañas araneomorfas de la familia Linyphiidae. Se encuentran en la región paleártica; muchas de ellas son cavernícolas.
Lista de especies
Se reconocen las siguientes según The World Spider Catalog 19.5:[1]
- Troglohyphantes adjaricus Tanasevitch, 1987
- Troglohyphantes affinis (Kulczyński, 1914)
- Troglohyphantes affirmatus (Simon, 1913)
- Troglohyphantes albicaudatus Bosmans, 2006
- Troglohyphantes albopictus Pesarini, 1989
- Troglohyphantes alluaudi Fage, 1919
- Troglohyphantes apenninicus Isaia, Mammola & Pantini, 2017
- Troglohyphantes balazuci Dresco, 1956
- Troglohyphantes birsteini Charitonov, 1947
- Troglohyphantes bolivarorum Machado, 1939
- Troglohyphantes bolognai Brignoli, 1975
- Troglohyphantes bornensis Isaia & Pantini, 2008
- Troglohyphantes boudewijni Deeleman-Reinhold, 1974
- Troglohyphantes brevipes Deeleman-Reinhold, 1978
- Troglohyphantes brignolii Deeleman-Reinhold, 1978
- Troglohyphantes bureschianus Deltshev, 1975
- Troglohyphantes caecus Fage, 1919
- Troglohyphantes caligatus Pesarini, 1989
- Troglohyphantes cantabricus Simon, 1911
- Troglohyphantes caporiaccoi Brignoli, 1971
- Troglohyphantes cavadinii Pesarini, 1989
- Troglohyphantes cerberus (Simon, 1884)
- Troglohyphantes charitonovi Tanasevitch, 1987
- Troglohyphantes cirtensis (Simon, 1910)
- Troglohyphantes comottii Pesarini, 1989
- Troglohyphantes confusus Kratochvíl, 1939
- Troglohyphantes croaticus (Chyzer, 1894)
- Troglohyphantes cruentus Brignoli, 1971
- Troglohyphantes dalmaticus (Kulczyński, 1914)
- Troglohyphantes deelemanae Tanasevitch, 1987
- Troglohyphantes dekkingae Deeleman-Reinhold, 1978
- Troglohyphantes diabolicus Deeleman-Reinhold, 1978
- Troglohyphantes dinaricus (Kratochvíl, 1948)
- Troglohyphantes diurnus Kratochvíl, 1932
- Troglohyphantes dominici Pesarini, 1988
- Troglohyphantes draconis Deeleman-Reinhold, 1978
- Troglohyphantes drenskii Deltshev, 1973
- Troglohyphantes excavatus Fage, 1919
- Troglohyphantes exul Thaler, 1987
- Troglohyphantes fagei Roewer, 1931
- Troglohyphantes fallax Deeleman-Reinhold, 1978
- Troglohyphantes fatalis Pesarini, 1988
- Troglohyphantes fugax (Kulczyński, 1914)
- Troglohyphantes furcifer (Simon, 1884)
- Troglohyphantes gamsi Deeleman-Reinhold, 1978
- Troglohyphantes gestroi Fage, 1933
- Troglohyphantes giachinoi Isaia & Mammola, 2018
- Troglohyphantes giromettai (Kulczyński, 1914)
- Troglohyphantes gladius Wunderlich, 1995
- Troglohyphantes gracilis Fage, 1919
- Troglohyphantes gregori (Miller, 1947)
- Troglohyphantes hadzii Kratochvíl, 1934
- Troglohyphantes helsdingeni Deeleman-Reinhold, 1978
- Troglohyphantes henroti Dresco, 1956
- Troglohyphantes herculanus (Kulczyński, 1894)
- Troglohyphantes inermis Deeleman-Reinhold, 1978
- Troglohyphantes iulianae Brignoli, 1971
- Troglohyphantes jamatus Roewer, 1931
- Troglohyphantes jeanneli Dumitrescu & Georgescu, 1970
- Troglohyphantes juris Thaler, 1982
- Troglohyphantes karawankorum Deeleman-Reinhold, 1978
- Troglohyphantes karolianus Topçu, Türkes & Seyyar, 2008
- Troglohyphantes konradi Brignoli, 1975
- Troglohyphantes kordunlikanus Deeleman-Reinhold, 1978
- Troglohyphantes kratochvili Drensky, 1935
- Troglohyphantes labrada Wunderlich, 2012
- Troglohyphantes lanai Isaia & Pantini, 2010
- Troglohyphantes latzeli Thaler, 1986
- Troglohyphantes lesserti Kratochvíl, 1935
- Troglohyphantes lessinensis Caporiacco, 1936
- Troglohyphantes liburnicus Caporiacco, 1927
- Troglohyphantes lucifer Isaia, Mammola & Pantini, 2017
- Troglohyphantes lucifuga (Simon, 1884)
- Troglohyphantes marqueti (Simon, 1884)
- Troglohyphantes microcymbium Pesarini, 2001
- Troglohyphantes milleri (Kratochvíl, 1948)
- Troglohyphantes montanus Absolon & Kratochvíl, 1932
- Troglohyphantes nigraerosae Brignoli, 1971
- Troglohyphantes noricus (Thaler & Polenec, 1974)
- Troglohyphantes novicordis Thaler, 1978
- Troglohyphantes numidus (Simon, 1911)
- Troglohyphantes nyctalops Simon, 1911
- Troglohyphantes orghidani Dumitrescu & Georgescu, 1977
- Troglohyphantes oromii (Ribera & Blasco, 1986)
- Troglohyphantes orpheus (Simon, 1884)
- Troglohyphantes paulusi Thaler, 2002
- Troglohyphantes pavesii Pesarini, 1988
- Troglohyphantes pedemontanus (Gozo, 1908)
- Troglohyphantes phragmitis (Simon, 1884)
- Troglohyphantes pisidicus Brignoli, 1971
- Troglohyphantes pluto Caporiacco, 1938
- Troglohyphantes poleneci Wiehle, 1964
- Troglohyphantes polyophthalmus Joseph, 1881
- Troglohyphantes pretneri Deeleman-Reinhold, 1978
- Troglohyphantes pugnax Deeleman-Reinhold, 1978
- Troglohyphantes pumilio Denis, 1959
- Troglohyphantes pyrenaeus Simon, 1907
- Troglohyphantes racovitzai Dumitrescu & Georgescu, 1970
- Troglohyphantes regalini Pesarini, 1989
- Troglohyphantes roberti Deeleman-Reinhold, 1978
- Troglohyphantes roquensis Barrientos & Fernández-Pérez, 2018
- Troglohyphantes ruffoi Caporiacco, 1936
- Troglohyphantes salax (Kulczyński, 1914)
- Troglohyphantes saouaf Bosmans, 2006
- Troglohyphantes sbordonii Brignoli, 1975
- Troglohyphantes schenkeli (Miller, 1937)
- Troglohyphantes sciakyi Pesarini, 1989
- Troglohyphantes scientificus Deeleman-Reinhold, 1978
- Troglohyphantes similis Fage, 1919
- Troglohyphantes simoni Fage, 1919
- Troglohyphantes sketi Deeleman-Reinhold, 1978
- Troglohyphantes solitarius Fage, 1919
- Troglohyphantes sordellii (Pavesi, 1875)
- Troglohyphantes spatulifer Pesarini, 2001
- Troglohyphantes spinipes Fage, 1919
- Troglohyphantes strandi Absolon & Kratochvíl, 1932
- Troglohyphantes subalpinus Thaler, 1967
- Troglohyphantes svilajensis (Kratochvíl, 1948)
- Troglohyphantes tauriscus Thaler, 1982
- Troglohyphantes thaleri Miller & Polenec, 1975
- Troglohyphantes trispinosus Miller & Polenec, 1975
- Troglohyphantes troglodytes (Kulczyński, 1914)
- Troglohyphantes turcicus Topçu, Türkeş, Seyyar, Demircan & Karabulut, 2014
- Troglohyphantes typhlonetiformis Absolon & Kratochvíl, 1932
- Troglohyphantes vicinus Miller & Polenec, 1975
- Troglohyphantes vignai Brignoli, 1971
- Troglohyphantes wiebesi Deeleman-Reinhold, 1978
- Troglohyphantes wiehlei Miller & Polenec, 1975
- Troglohyphantes zanoni Pesarini, 1988
Referencias
Enlaces externos
- Wikispecies tiene un artículo sobre Troglohyphantes.
- En ION
- Nomenclator Zoologicus